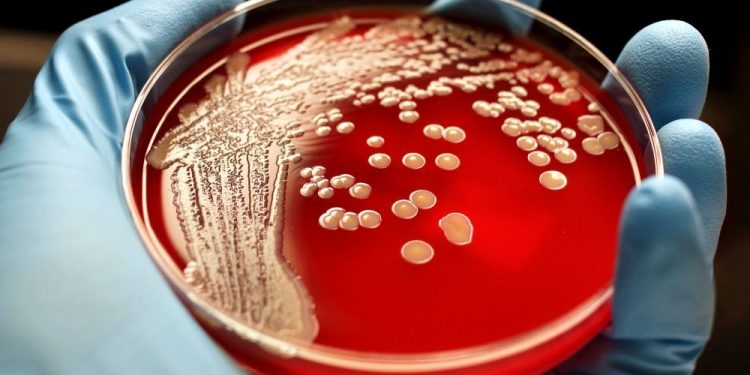
СІБІР ЖАРАСЫ: АУРУДЫҢ БЕЛГІЛЕРІ МЕН АЛДЫН АЛУ ШАРАЛАРЫ

Сібір жарасы- дене қызуының көтерілуі және лимфа жүйесінің зақымдануымен, ағзаның ауыр улануымен жүретін зоонозды инфекция. Сібір жарасы-терілік, өкпелік, ішектік және сепсистік түрлерде болуы мүмкін.
Түркістан облысында 2023 жылы және 2024 жылдың бүгінгі күніне дейін расталған жағдайлар тіркелген жоқ.
Сібір жарасының қоздырғышы – Bacillus anthracis бацилласы. Ол сыртқы ортаға өте төзімді, спора түрінде топырақта 100 жылға дейін белсенділігін жоғалтпайды. Адамға жұқтырушы көзі – үй жануарлары (ірі қара мал, қой, ешкі, түйе, және т.б.) болып табылады.
Адам инфекцияны мал сойғанда, малға күтім көрсеткенде, асқа ауру малдың етін, сүтін қабылдағанда, споралары бар терісімен жанасқанда жұқтырады. Ал ауру адамнан адамға жұқпайды. Аурудың формасына байланысты адамда дене қызуының көтерілуі, тері жарасы, ісіну, ауыр формаларында қанды іш өту және құсу, ішінің ауыруы, өкпе аурулары, жүрек әлсіздігі пайда болады. Емдеусіз ауру өліммен аяқталады.
Сібір жарасының белгілері мен аурудың ағымы. Ауру көбінесі тері жамылғысын зақымдайды, сирек түрде ішкі мүшелерді де зақымдауы мүмкін.
Сібір жарасының инкубация кезеңінің ұзақтығы күнтізбелік 8 (сегіз) күнді құрайды (түріне қарай 14 күнге дейін созылуы мүмкін).
Адамда ауру 90-95% дейін терілік формада болады. Терілік форма 80% жағдайда жеңіл түрде, 20% ауыр түрде өтеді. Дер кезінде емделмеген немесе кеш емделген терілік түрде өлім 5% дейін жетеді. Ішектік формада ауру- ауыр уланумен, геморрагиялық энтероколитпен көрініс береді, үрдіс аз уақытта сепсиске ұласады. Өкпелік түрінде ауыр геморрагиялық плевропневмония дамиды. Өкпелік-ішектік формаларында өлім 80-100% дейін жетеді. Терілік түрінде қоздырғыш енген жерде алдыменен диаметрі 1-2 см, қызыл-көкшіл түсті, ауырмайтын дақ пайда болады. Сол жер қышиды, ашиды. Бірнеше сағаттан кейін дақтың орнында мыстың түсіндей папула пайда болады. 12-24 сағаттан кейін іші серозды, соңынан қанды сұйықтыққа толы везикулаға айналады. Осы везикула жарылғаннан кейін, жиектері көтеріңкі, түбі қоңыр түсті жараға (карбункул) айналады.
Жараның айналасы қызарып, ісіп тұрады. 1-2 аптадан кейін карбункулдың ортасы қарайған тығыз, ауырмайтын некрозды қабыршаққа ауысады. Осы қабыршақ айналасындағы қызарған терінің ортасындағы қара дақ, көміртәрізді көрінеді. (Сондықтан оның аты грек тілінен аударғанда «anthax – көмір» деген мағынаны білдіреді.) Онда сезімдалдық мүлде болмайды. Лимфа түйіндерінің ұлғаюы болады. 2-3 аптаның соңына қарай қабыршақ түсіп, оның орны тыртықтанады. Карбункулдың ең көп ораналасатын жерлері – аяқ-қол, мойын және желке. Жергілікті қабыну процесі кезінде ағзаның жалпы улану белгілері болады. Әлсіздік, шаршағыштық, басының ауыруы, дене қызуы субфебрильдіден, 39-40ºС дейін көтеріледі. Үрдістің сепсиске ұласуы қоздырғыштың тыныс алу, асқазан ішек жолдарына енген жағдайында дамиды. Терілік формада оның сепсиске ұласуы сирек кездеседі.
Аурудың бастапқы кезеңіндегі айтылған белгілер байқалған жағдайда науқас немесе ол жақындарымен міндетті түрде ауруханаға жеткізіліп медициналық көмекке жүгінуі қажет. Дәрігерге дер кезінде қаралғанда және арнайы емдеу шараларын жүргізгенде дерттен толығымен жазылып кетуге болады.
Сібір жарасының ең тиімді алдын алу шарасы — жыл сайынғы тиісті контингенттерді ауруға қарсы егу жүргізу. Ауруға қарсы вакцинаны егу- үй жануарларымен, ет комбинаттарында, мал шаруашылығында тұрақты жұмыс істейтіндерге, тері-жүн өңдеуге, тасымалдауға, сақтауға, сұрыптауға, илеуге қатысатын адамдарға егіледі. Адам ағзасында Сібір жарасына төтеп бере алу қасиеті егуден кейінгі 12-14 күнде пайда болады да, 12 айға жуық сақталады және жыл сайын қайта екпе алып отырулары қажет.
Сібір жарасын жұқтырушы көзі ретінде үй жануарларына екпе жүргізу ең тиімді тәсіл болып табылдады.
Профилактикалық екпемен ауылшаруашылық малдары түгел қамтылуы тиіс.
Алдын алу шаралары: Сібір жарасына күдіктелген жануарларды дереу оқшалау, жануарлардың әкелінуі мен әкетілуін, ет, сүт және тері шикізаттарының шығарылуын болдырмау. Барлық күдікті жағдайлар жайлы дереу ветеринарлық мекемелерге ақпарат беру. Малды сояр, әсіресе мәжбүрлі сояр алдында ветеринарды міндетті түрде шақыру. Ауру малдың еті мен басқа өнімдерін зертханалық зерттеусіз тамаққа және т.б. мақсаттарда пайдалануға жол бермеу қажет.
Нышанов Нұрбек Садықбекұлы
ҚР ДСМ СЭБК Түркістан облысының санитариялық-эпидемиологиялық бақылау департаменті басшысы